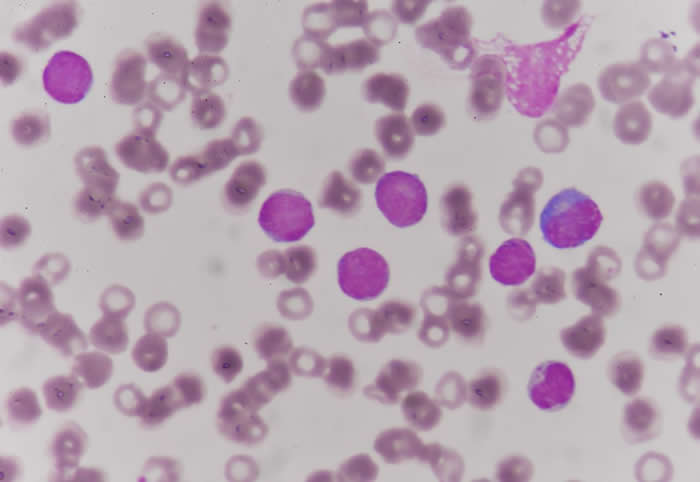
��̼�����ƣ�С�մ����ƻ��ܰ���Ԥ����ϸ����ֲ��İ�Ѫ������

用碳酸氢钠(小苏打)治疗或能帮助预防干细胞移植后的白血病复发
用碳酸氢钠(小苏打)治疗或能帮助预防干细胞移植后的白血病复发
(蜘蛛网eeook.com报道)据EurekAlert!:科学家发现,碳酸氢钠(也称为发酵粉或小苏打)可对白血病患者的T细胞进行重新编程而抵抗癌细胞的免疫抑制作用;癌细胞的免疫抑制作用可以导致干细胞移植后的白血病复发。这项研究阐明了患者在移植后经常复发的原因,并为测试碳酸氢钠作为降低复发率和改善治疗结果的安全简单的治疗奠定了基础。
同种异体造血细胞移植是干细胞移植的一种形式,它有时能治愈诸如急性髓性白血病(AML)等血癌患者。然而,在干细胞移植100天后,完全缓解率可能低至17%;这主要是因为白血病经常会复发。人们迫切需要能增强干细胞移植抗癌作用的方法,但研究人员还不完全了解为什么捐赠的T细胞常常无法杀死肿瘤。
通过研究小鼠的白血病模型和患者在移植前后的T细胞,Franziska Uhl和同事发现,AML细胞可通过分泌乳酸而抑制代谢活动及捐赠T细胞的播散;乳酸能使细胞环境酸化并干扰葡萄糖代谢。为寻找治疗方法,该研究小组转而关注抗酸剂碳酸氢钠;他们在10例接受移植后AML复发的患者中发现,一种名为bicaNorm的碳酸氢钠临床制剂可逆转这些对T细胞的抑制作用。
作者呼吁对更多患者进行试验以更好地确定碳酸氢钠对接受干细胞移植者的长期裨益。